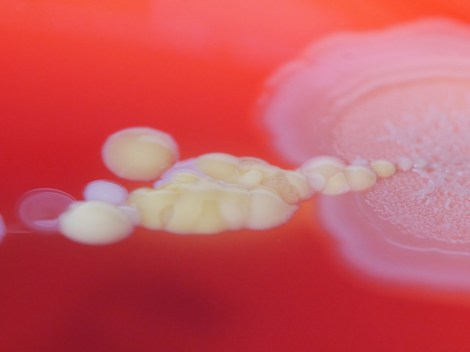

Cambrian creation

by Abigail Harris
Over the past few months our researchers have been working with University of Plymouth illustration student Abigail Harris, who has delved into the weird and wonderful world of some of the earliest animals. Here, Abigail tells us about the process that led to the creation of her Cambrian artwork, inspired by our First Animals exhibition.
I first visited the Museum in April this year when I was given the opportunity to collaborate with scientists as part of a module in my BA in at the University of Plymouth. Things kicked off with a short talk about the Ediacaran and Cambrian geological periods, when Earth’s first animal life started to appear.
I quickly narrowed my interest down to fossils from the Cambrian period which are more complex life forms, more similar to life today. A collection of small fossils from the Chengjiang fossil site in Yunnan province, China was the inspiration for some initial observational drawings.


After returning to Plymouth University, I began to develop these initial sketches and observations, continuing to research the Chengjiang material and learning more about the characteristics of some of the creatures preserved as fossils.
I wanted to create an under-the-sea ecology reconstruction showing a diversity of life forms, focusing on Onychodictyon, Cotyledion, Cricocosmia, Luolishania, and Paradiagoniella.
A five-step process was used for each reconstruction. Initially, I would sketch the fossil as I saw it, then I would research the characteristics and features of that animal, making a list of things to include in my drawing. A second drawing would then include all of these characteristics, not just what was initially visible in the fossil.
These rough sketches were then sent to the scientists for feedback, helping me to redraw and paint the illustrations with watercolour, before scanning and digitally editing each painting. Lastly, I created a background and added my illustrations.

Although the reconstructions were not completely finished by the time of my project deadline, I returned to the Museum in July and was given a tour of the First Animals exhibition by Deputy Head of Research Imran Rahman, as well as the opportunity to discuss how to improve my artworks for accuracy.
Another round of sketching and painting led to the final piece, shown at the start of this article, complete with an added digital background of the seafloor, and darkened to reflect the murky world of a Cambrian ocean, 50 metres below the surface.









The Beautiful Bacteria project was funded by